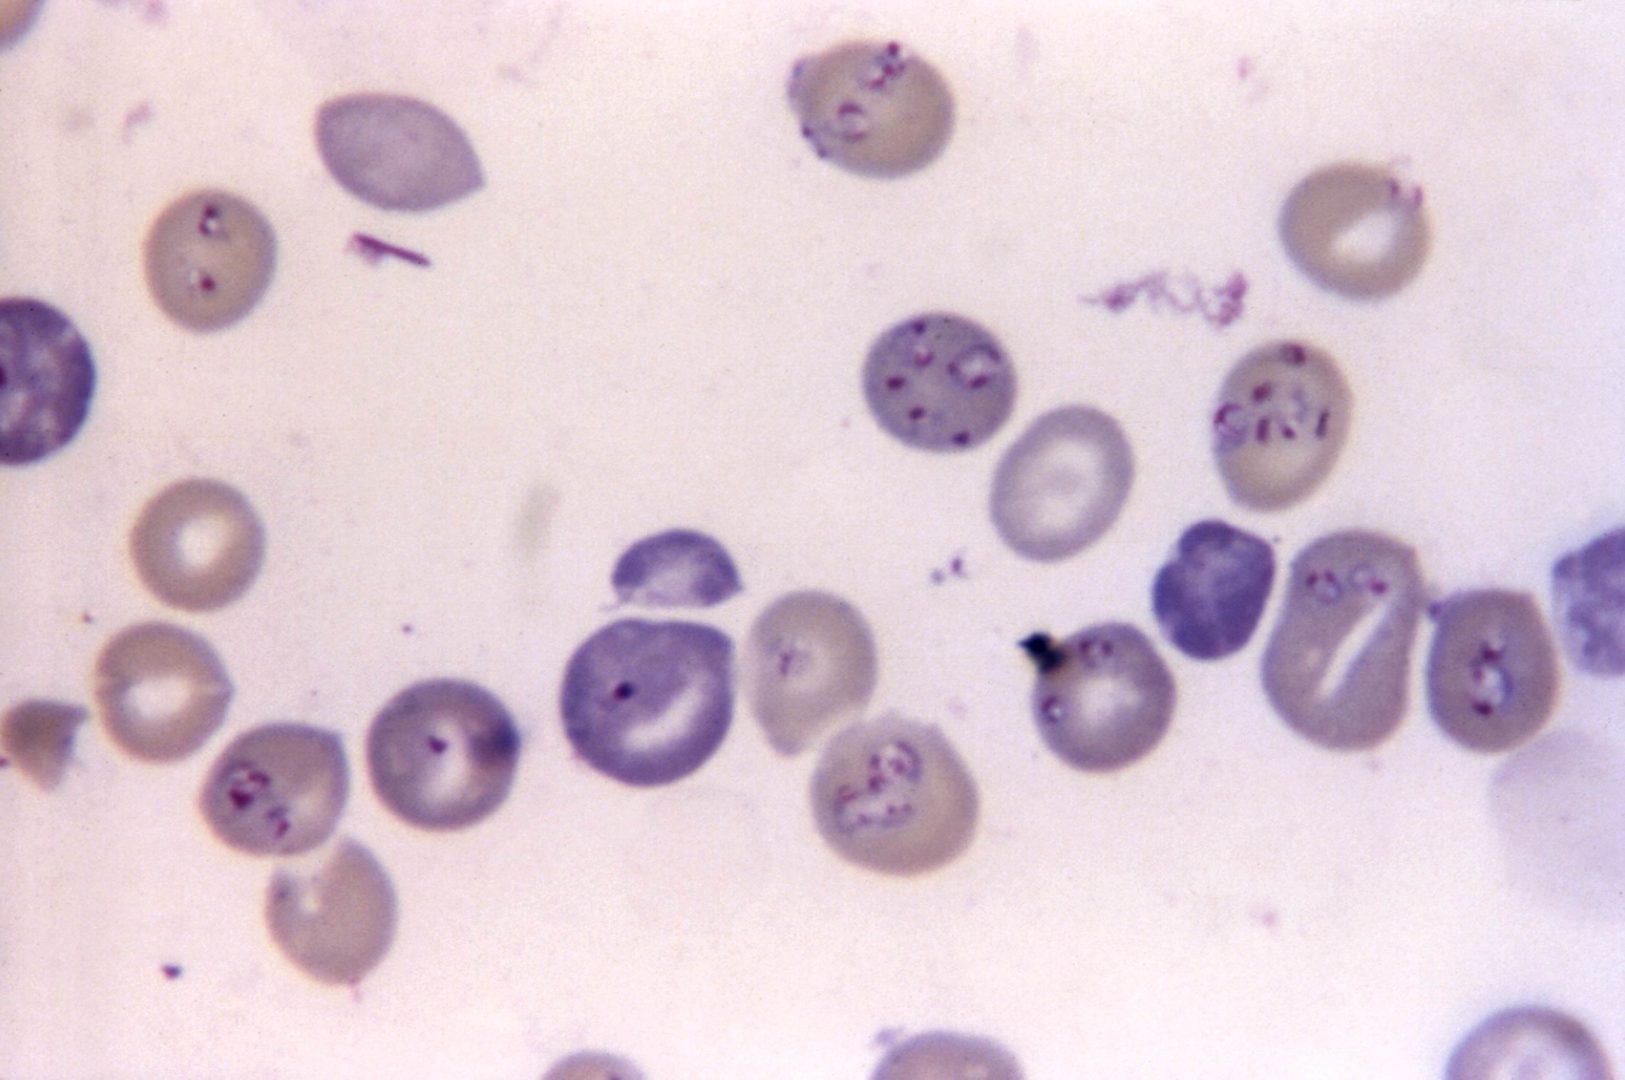
I tre parassiti pericolosi più comuni nell’uomo: come ci infettiamo e cosa succede

Un brano adattato alle esigenze del partito ha reso la Germania di Tacito una delle più grandi fonti in cui...
Leggi tutto
Cosa hanno in comune “One Piece” e Dante Alighieri? Vediamo come entrambi strutturano una prigione
Daria Donato – 11 Maggio 2026
Cos’è lo Star Wars Day? Scopriamo questo e come questi film mostrano la realtà
Daria Donato – 4 Maggio 2026
Il fango delle trincee plasma il linguaggio tra i canti alpini e l’officina gaddiana
Maria Geraci – 27 Aprile 2026
Vediamo come “One Piece” riprende un grande insegnamento di Cicerone ripreso anche da Churchill
Daria Donato – 27 Aprile 2026
Cosa hanno in comune “Bear nella grande casa blu”, Leopardi e Zarathustra? Scopriamolo
Daria Donato – 20 Aprile 2026
Tower Rush Arnaque Jouer Maintenant Sans Risque et Sans Frais
Francesco Masciavè – 10 Aprile 2026
The Next 3 Things You Should Do For Kukimuki Success
Elena Rondelli – 9 Aprile 2026
Il viaggio è un chiasmo completo o incompleto? Vediamolo con l’esempio del naufragio
Daria Donato – 6 Aprile 2026
Le radici antiche della Pasqua tra la rinascita primaverile e le persistenze dei riti precristiani
Maria Geraci – 6 Aprile 2026
John Steinbeck trasforma gli emarginati di Monterey negli eroi moderni di un nuovo ciclo arturiano
Maria Geraci – 31 Marzo 2026